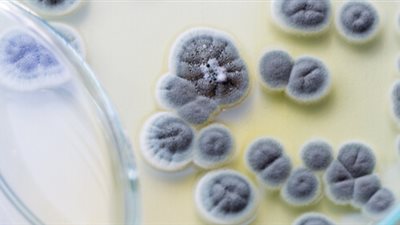
txt

كيف يؤثر تناول اللوز على صحة الدماغ؟

يُروَّج للوز كثيرًا كأحد أكثر الأطعمة الصحية، وقد وجدت دراسة حديثة أجراها علماء أمريكيون أن للوز قدرة على التأثير على وظائف الدماغ وقد وجد الخبراء أن تناول اللوز يؤثر على القدرات الإدراكية.
لهذا السبب.. يؤثر اللوز على الدماغ
توصل مؤلفو الدراسة، وهم موظفون في جامعة بيردو، إلى أن اللوز يُحسّن عملية التفكير ويعتقد الباحثون أن تناول اللوز مع الغداء مفيدٌ بشكل خاص.
وقال الباحثون إن "تناول اللوز في وجبة الغداء قد يكون فعالا في الحفاظ على الأداء الإدراكي في فترة ما بعد الظهر".
خلال التجارب، راقب الباحثون 86 مشاركًا بالغًا في مجموعتين لمدة 12 أسبوعًا، أُضيف اللوز إلى نظام إحدى المجموعتين الغذائي، بينما لم تتناول المجموعة الأخرى أي مكسرات.
خضع المشاركون في كلتا المجموعتين لاختبارات تتعلق بذاكرتهم وتركيزهم، أظهرت هذه الاختبارات أن الأشخاص الذين تناولوا اللوز أثناء الغداء كانوا أقل عرضة للتدهور المعرفي الذي يحدث عادةً في النصف الثاني من اليوم، إذ كانوا أفضل في تذكر الكلمات وإنجاز المهام من أولئك الذين لم يتناولوا اللوز.

تابعوا آخر أخبار بوابة الوفد الإلكترونية عبر نبض
تابعوا آخر أخبار بوابة الوفد الإلكترونية عبر نبض